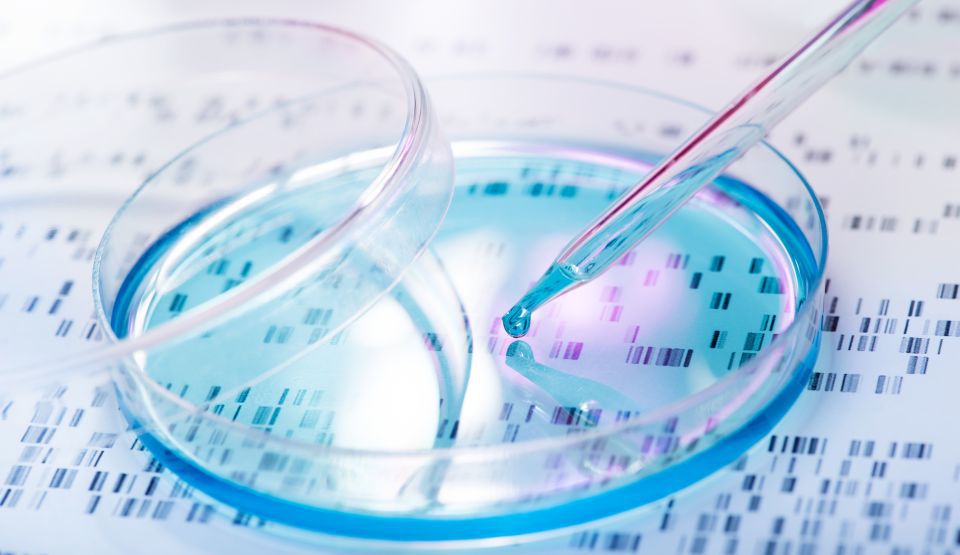

:format(webp):quality(90)/https://www.descopera.ro/wp-content/uploads/2019/10/18431830/1-hiv-123rf-descopera.jpg)
Departamentul pentru Securitate Internă (DHS) lucrează în prezent pentru un program care să permită Washingtonului obţinerea de informaţii genetice din partea celor care intră ilegal pe teritoriul Statelor Unite şi, totodată, înregistrarea acestor informaţii într-o bază de date aparţinând Biroului Federal de Investigaţii (FBI), numită CODIS, prin intermediul căreia profilele persoanelor arestate sau suspectate de săvârşirea de infracţiuni, pot fi identificate, potrivit agenţiei de presă Mediafax.
Numărul mutaţiilor genetice din ADN-ul unui nou născut variază în funcţie de părinţii acestuia
Numărul mutaţiilor genetice din ADN-ul unui nou născut variază în funcţie de părinţii acestuiaAceste informaţii ar putea fi utilizate şi de alte organisme responsabile de menţinerea ordinii. Reprezentanţi din partea DSH au anunţat, sub condiţia anonimatului, faptul că de această măsură vor beneficia şi agenţii frontierelor de stat, care vor avea posibilitatea unei monitorizări corecte a numărului de migranţi prezenţi pe teritoriul statului.
„Aceasta ne va permite îmbunătăţirea capacităţii noastre de a identifica o persoană intrată în mod ilegal în ţară” şi „va ajuta, totodată, orrganismele noastre”, au declarat oficiali din cadrul Departamentului de Securitate Internă.
În anul 2018, mai mult de 396.000 de persoane au fost reţinute la graniţa Statelor Unite cu Mexic, majoritatea provenind din El Salvador, Honduras şi Guatemala.